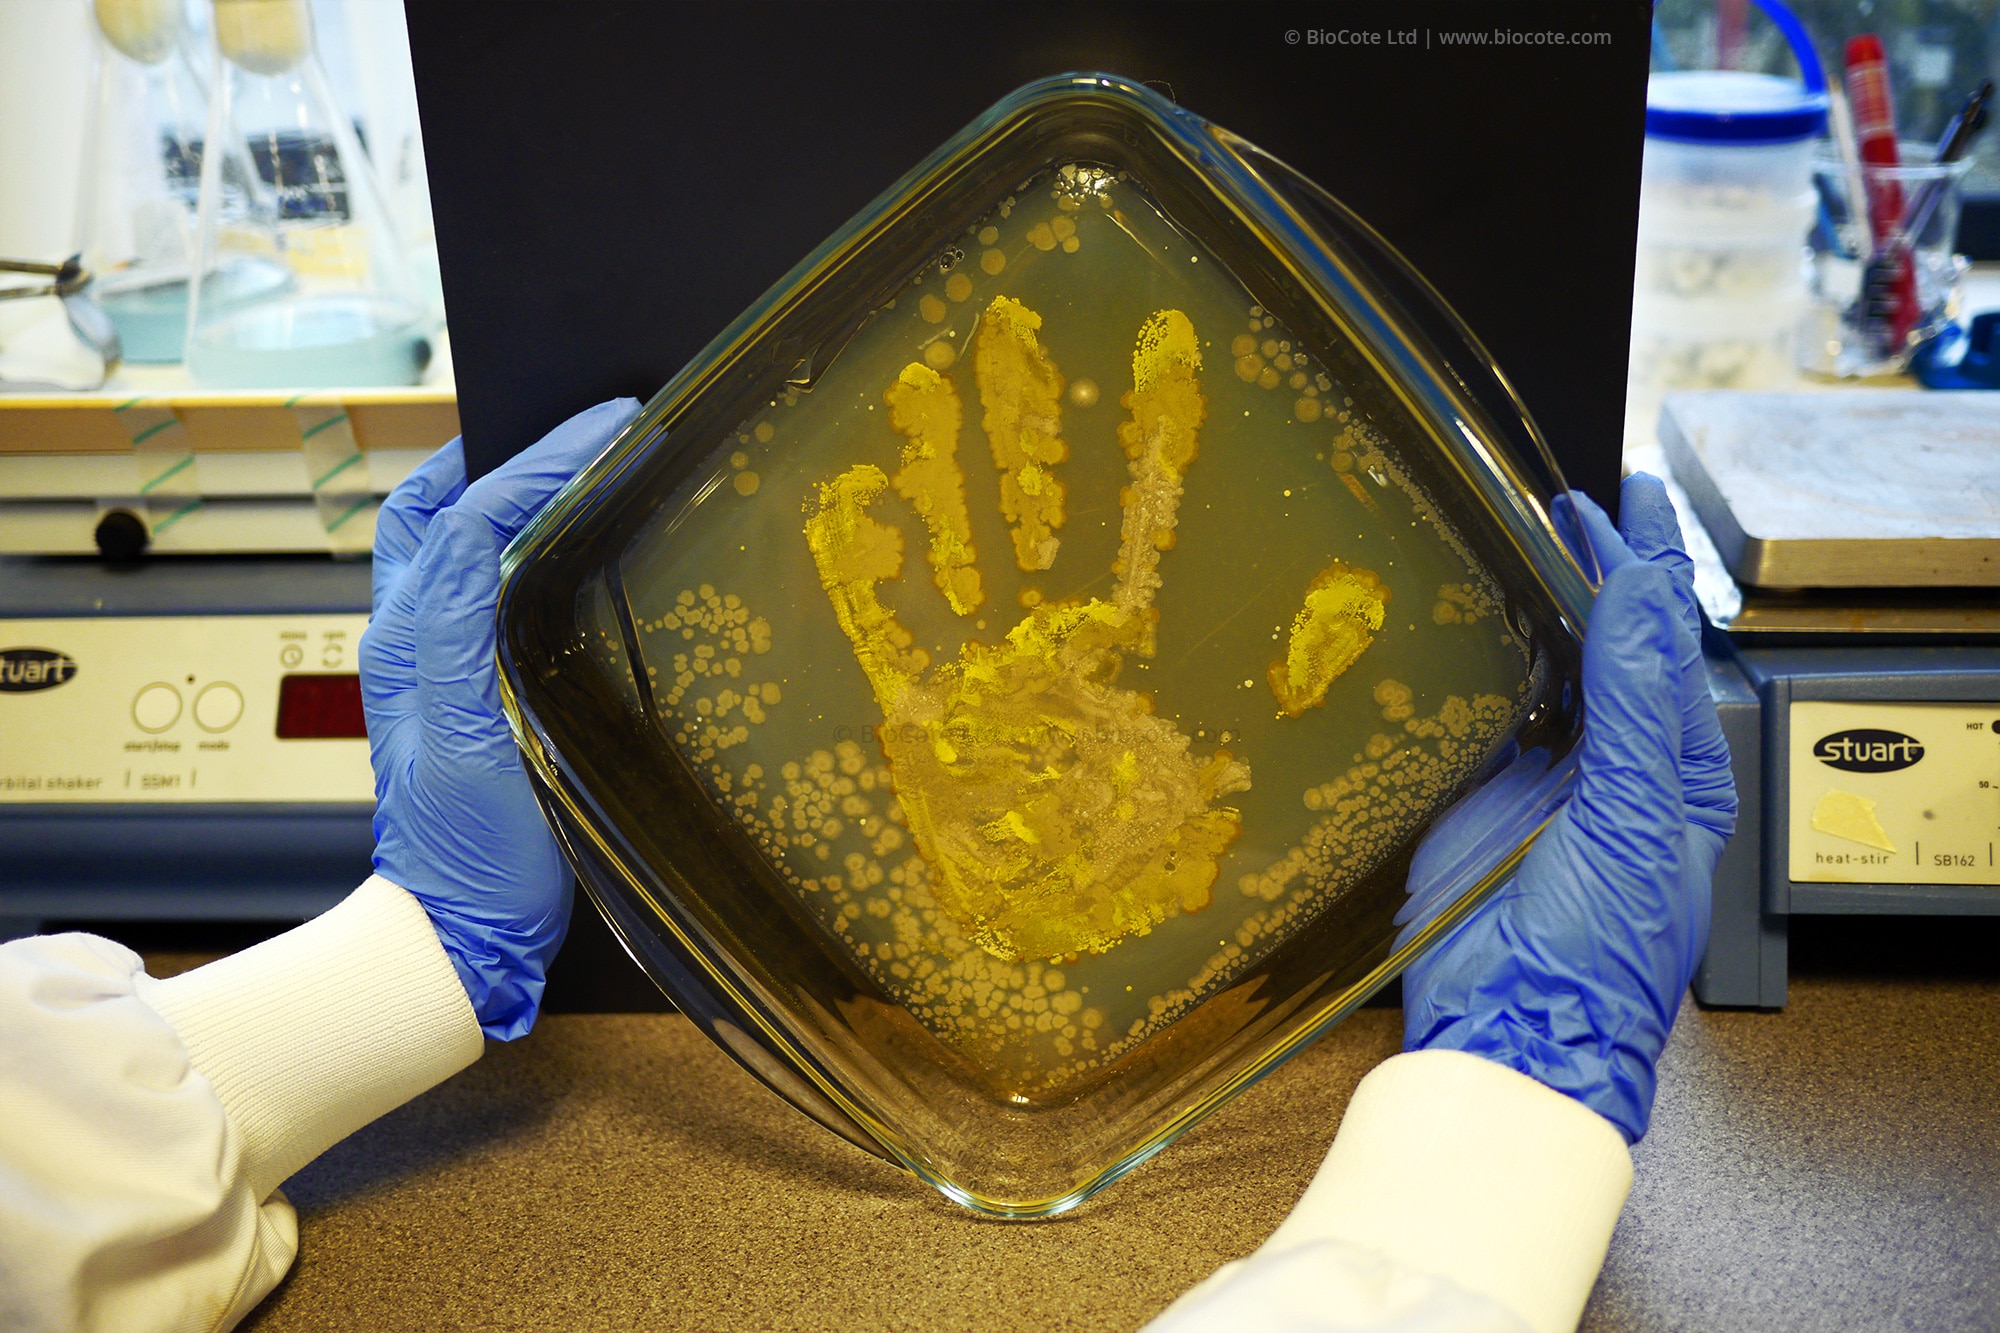

Per neutralizzare l’accumulo di microbi, le maniglie Valli & Valli sono ora trattate con lo speciale trattamento antimicrobico BioCote che risponde all’esigenza sempre più diffusa di buone pratiche di igiene negli edifici.
La tecnologia Biocote
La tecnologia BioCote assicura un’efficace protezione del rivestimento della maniglia creando uno strato protettivo che riduce continuamente la presenza di microbi sulla superficie.
Questo speciale additivo, che si aggiunge alla vernice in fase di produzione, riduce notevolmente il rischio di cross contamination e contrasta sin da subito e in modo duraturo la proliferazione dei batteri sino al 99,5%.

I rivestimenti antimicrobici applicati alle maniglie Valli & Valli completano quindi perfettamente le normali pratiche di pulizia garantendo una maggiore igiene e prestazioni del rivestimento, proprio negli ambienti in cui l’igiene è assolutamente necessaria.




